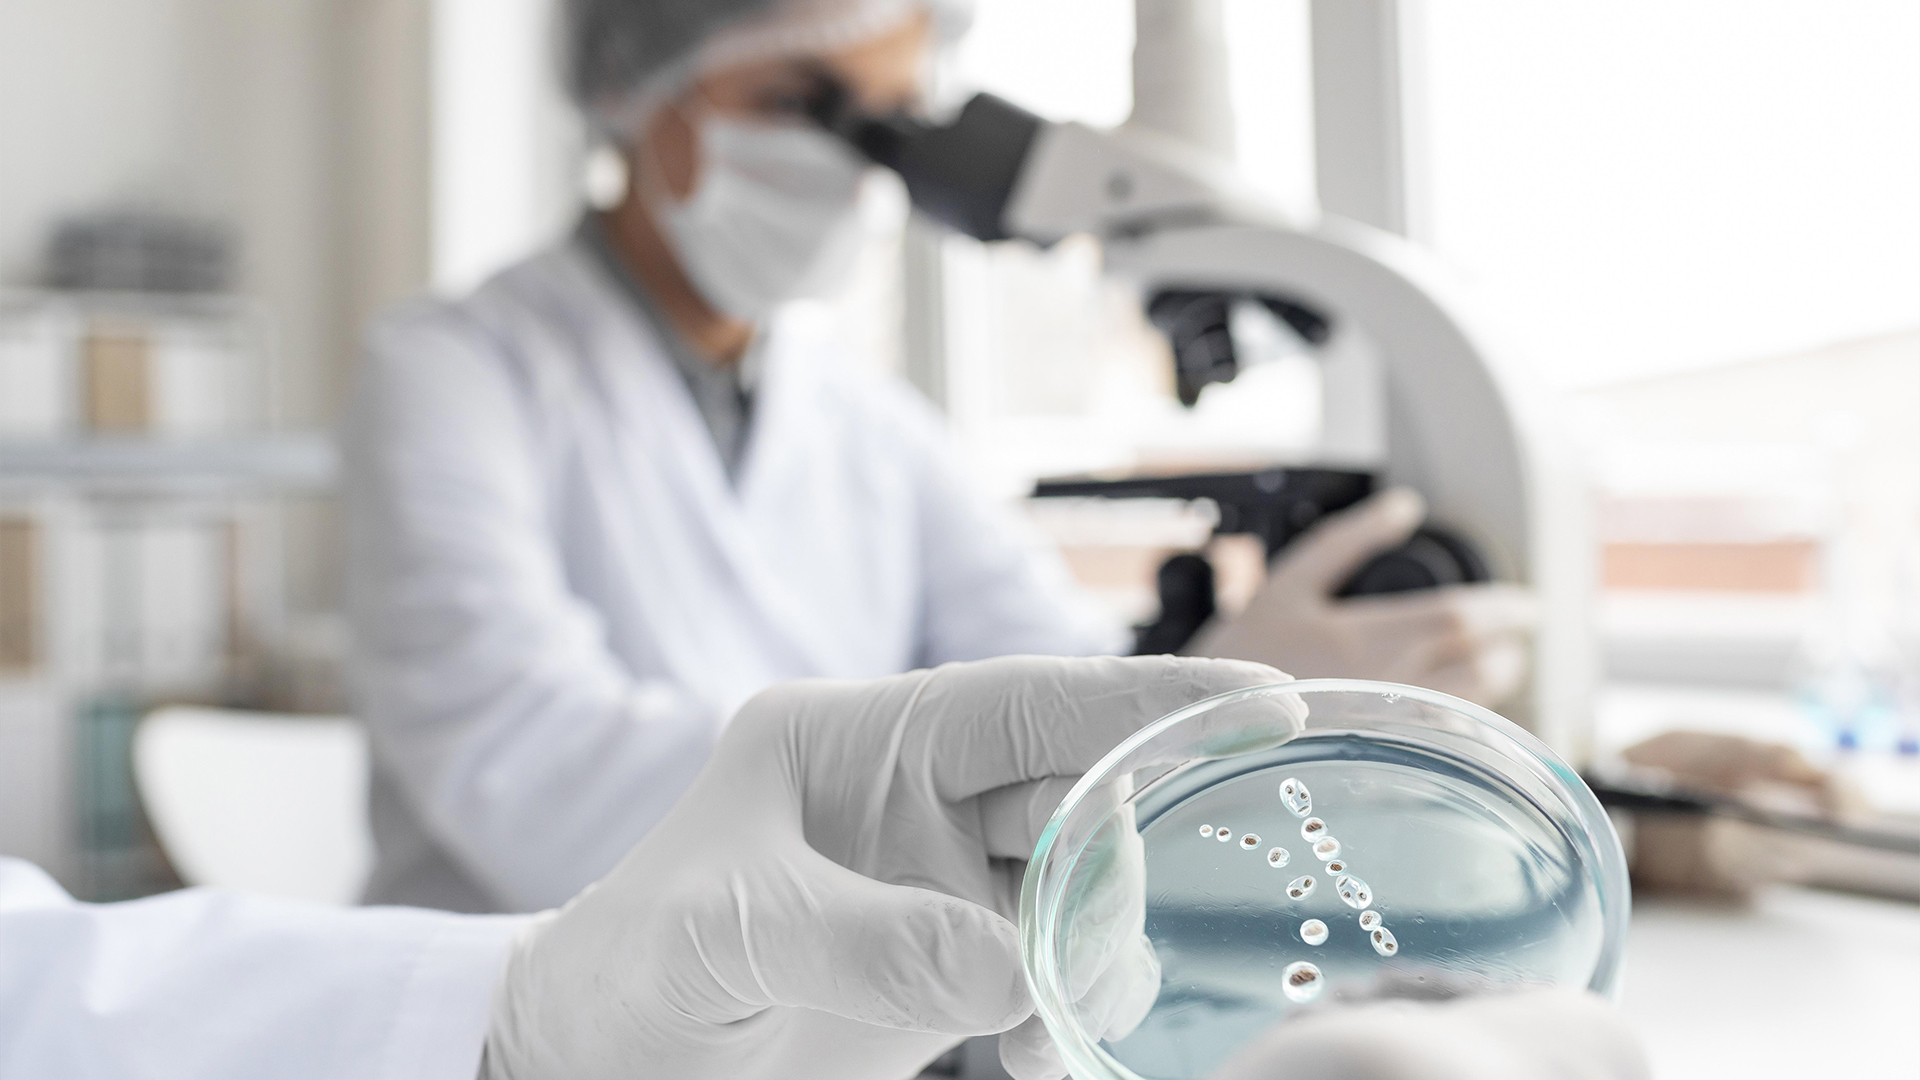
Image

Repenser l’univers visuel de la marque à travers une série d’images incarnant rigueur, précision et projection technologique.
✦ Contexte
Conformat conçoit et installe des environnements critiques pour la recherche scientifique, l’industrie pharmaceutique ou l’aérospatiale.
Des lieux invisibles du grand public, mais essentiels à la fabrication du futur.
La marque avait besoin de rendre lisible ce qui ne se montre pas : son expertise, ses valeurs, sa vision.
Le défi : sortir du champ purement technique pour proposer un langage visuel qui raconte un rôle fondamental mais discret, entre technologie de pointe et exigence quasi-médicale.
✦ Problématique
Comment rendre tangible l’innovation silencieuse d’une entreprise comme Conformat, sans caricaturer le high-tech ni tomber dans les visuels clichés de laboratoire ou de tech générique ?
Comment créer un imaginaire visuellement puissant, cohérent, identifiable…
alors que le produit réel, lui, est souvent invisible ou abstrait (propreté de l’air, particules, normes ISO…) ?
✦ Concept & axe créatif
J’ai développé une approche narrative basée sur trois registres visuels imbriqués :
- Le Geste — Tout part de la main. Celle du technicien, du chercheur, du monteur.
→ Plans serrés, précision chirurgicale, lumière blanche. - La Matière — L’infiniment petit et la structure de l’invisible.
→ Fluides, composants, textures de surface, circulation de l’information. - L’Horizon — La projection. Un champ d’étoiles, une trajectoire, une vision long terme.
→ Métaphore cosmique, échelle augmentée, silence de l’espace.
Chaque image joue sur l’équilibre entre ces couches, créant un territoire visuel cohérent où science, humain et imagination coexistent.
✦ Direction artistique
- Palette : froide, neutre, clinique – mais rehaussée par des touches de bleu dense, de noir profond ou d’éclats lumineux
- Style photo : mélange de réalisme documentaire et de mise en scène maîtrisée
- Composition : lignes directrices nettes, plans ouverts pour l’espace, plans serrés pour l’expertise
- Émotion : retenue, concentration, projection — jamais surjouée, jamais marketing
✦ Résultat
Une série d’images conçues comme un langage de marque :
plus qu’une vitrine, un dispositif narratif qui positionne Conformat comme un facilitateur du progrès.
Un visuel peut raconter un métier.
Mais un système visuel peut ancrer une position, une promesse, un rôle dans l’écosystème.
C’est ce que cette DA propose : une lecture sensible d’une entreprise ultra-tech, à travers une esthétique maîtrisée, précise, et symbolique.
Voir le projet
Le projet conformat sur insta !
Détails du projet
Client
Conformat
Année
2025
Durée
1 semaine
Technologies
Vues
80 visiteurs
Équipe
Solo
Projets similaires
Vous avez un projet similaire ?
Parlons de vos besoins et voyons comment je peux vous accompagner de l'idée à la réalisation.